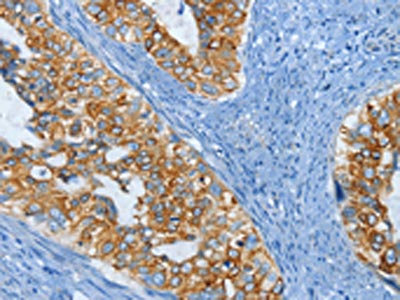

KRT81 Antibody
-
中文名稱:KRT81兔多克隆抗體
-
貨號:CSB-PA042926
-
規格:¥1100
-
圖片:
-
The image on the left is immunohistochemistry of paraffin-embedded Human cervical cancer tissue using CSB-PA042926(KRT81 Antibody) at dilution 1/15, on the right is treated with fusion protein. (Original magnification: ×200)
-
The image on the left is immunohistochemistry of paraffin-embedded Human breast cancer tissue using CSB-PA042926(KRT81 Antibody) at dilution 1/15, on the right is treated with fusion protein. (Original magnification: ×200)
-
Gel: 10%SDS-PAGE, Lysate: 40 μg, Lane: Hela cells, Primary antibody: CSB-PA042926(KRT81 Antibody) at dilution 1/200, Secondary antibody: Goat anti rabbit IgG at 1/8000 dilution, Exposure time: 30 seconds
-
-
其他:
產品詳情
-
Uniprot No.:
-
基因名:KRT81
-
別名:1 antibody; basic antibody; ghHb 1 antibody; ghHb1 antibody; ghHkb 1 antibody; ghHKb1 antibody; hair antibody; Hair keratin K2.9 antibody; Hard keratin type II 1 antibody; HB 1 antibody; HB1 antibody; hHAKB2 1 antibody; K2.9 antibody; K81 antibody; Keratin 81 antibody; Keratin antibody; Keratin hair basic 1 antibody; Keratin type II cuticular Hb1 antibody; Keratin-81 antibody; Keratin81 antibody; KRT 81 antibody; KRT81 antibody; KRT81_HUMAN antibody; KRTHB 1 antibody; KRTHB1 antibody; Metastatic lymph node 137 gene protein antibody; MLN 137 antibody; MLN137 antibody; type II cuticular Hb1 antibody; Type II hair keratin Hb1 antibody; Type-II keratin Kb21 antibody
-
宿主:Rabbit
-
反應種屬:Human,Mouse
-
免疫原:Fusion protein of Human KRT81
-
免疫原種屬:Homo sapiens (Human)
-
標記方式:Non-conjugated
-
抗體亞型:IgG
-
純化方式:Antigen affinity purification
-
濃度:It differs from different batches. Please contact us to confirm it.
-
保存緩沖液:-20°C, pH7.4 PBS, 0.05% NaN3, 40% Glycerol
-
產品提供形式:Liquid
-
應用范圍:ELISA,WB,IHC
-
推薦稀釋比:
Application Recommended Dilution ELISA 1:1000-1:2000 WB 1:200-1:1000 IHC 1:15-1:50 -
Protocols:
-
儲存條件:Upon receipt, store at -20°C or -80°C. Avoid repeated freeze.
-
貨期:Basically, we can dispatch the products out in 1-3 working days after receiving your orders. Delivery time maybe differs from different purchasing way or location, please kindly consult your local distributors for specific delivery time.
-
用途:For Research Use Only. Not for use in diagnostic or therapeutic procedures.
相關產品
靶點詳情
-
基因功能參考文獻:
- Results show that full size KRT81 is expressed in normal breast epithelial cells and breast cancer cells, and indicate that KRT81 contributes to the migration and invasion of breast cancer cells. PMID: 28405679
- The analysis of the KRT81rs3660G>C polymorphism may be useful to identify non-small cell lung cancer patients at high risk of a poor disease outcome. PMID: 25716425
- Novel mutations causing monilethrix are reported in KRT81, KRT83, and KRT86. PMID: 25557232
- MiRNA-related single nucleotide polymorphism sites of KRT81 is associated with non-Hodgkin's lymphoma. PMID: 24530479
- Overall survival was significantly longer in multiple myeloma patients with KRT81 rs3660 C/C variant PMID: 22539802
- KRT81 has emerged as a promising immunohistochemical marker for the identification of squamous cell lung carcinoma PMID: 21799879
- EBV-dependent upregulation of hHb1-DeltaN in gastric carcinoma cell lines PMID: 14520698
- The KRTHB1 expression uniformly occurred in the midcortex region. PMID: 15797458
- Transfected p65 induces transcriptional activation of Hb1. PMID: 18021261
顯示更多
收起更多
-
相關疾病:Monilethrix (MNLIX)
-
蛋白家族:Intermediate filament family
-
組織特異性:Abundantly expressed in the differentiating cortex of growing (anagen) hair. Expression is restricted to the keratinocytes of the hair cortex and is absent from inner root sheath and medulla. Expressed in malignant lymph node tissue in breast carcinoma ti
-
數據庫鏈接:
Most popular with customers
-
-
YWHAB Recombinant Monoclonal Antibody
Applications: ELISA, WB, IHC, IF, FC
Species Reactivity: Human, Mouse, Rat
-
Phospho-YAP1 (S127) Recombinant Monoclonal Antibody
Applications: ELISA, WB, IHC
Species Reactivity: Human
-
-
-
-
-